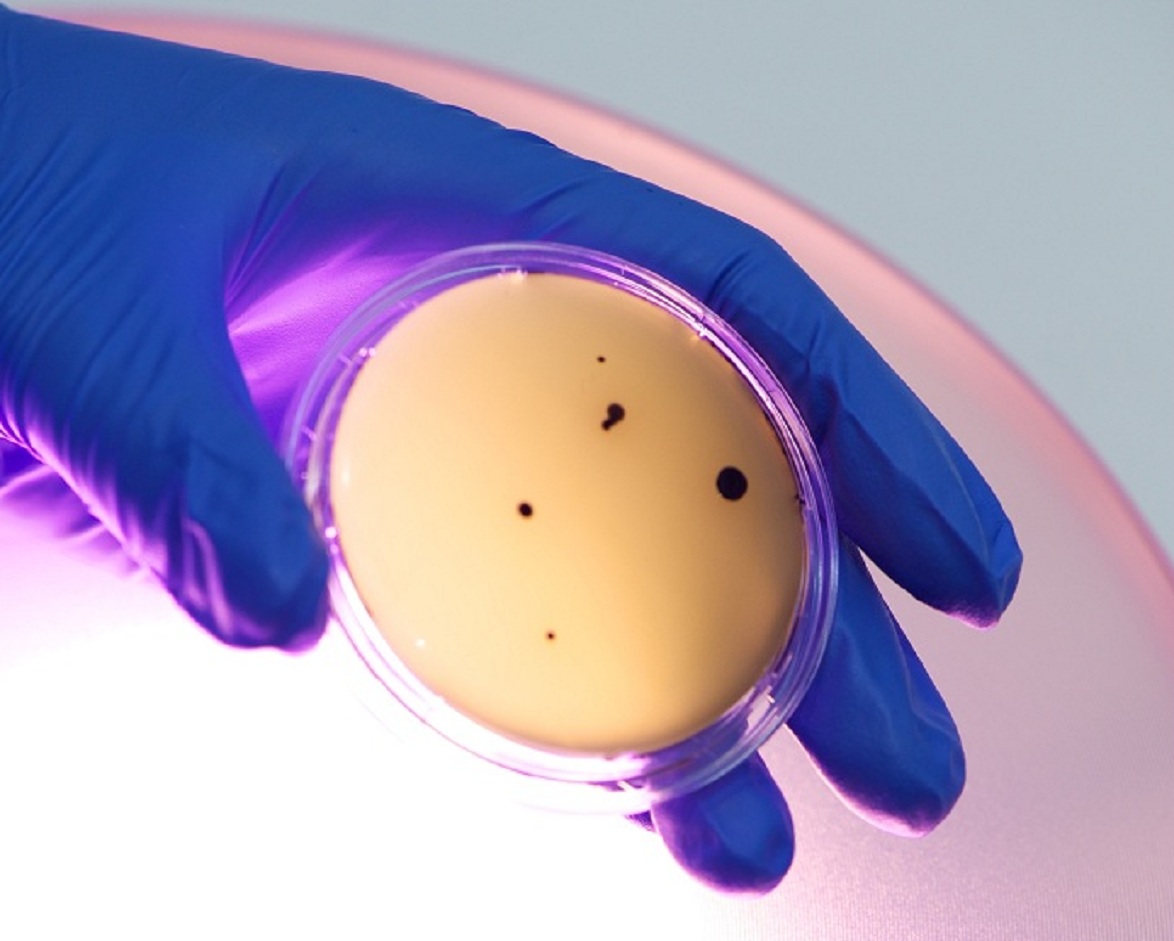

En general, los pacientes que contraen infecciones provocadas por bacterias denominadas habitualmente como fármaco resistentes tienen un peor pronóstico en el desarrollo de su enfermedad y un mayor riesgo de morir que las personas que están infectadas con bacterias de la misma especie pero sin que sean resistentes a dichos fármacos.
Esto, como es evidente, supone un grave problema para el control de estas infecciones. Por lo tanto, necesitamos con urgencia nuevas estrategias de diagnóstico que permitan dar un mejor uso a los antibióticos y, con ello, salvaguardar la eficacia tanto de los fármacos ya existentes como de los nuevos que se desarrollen en un futuro.
Un grupo de investigadores pertenecientes al Centro Wellcome Trust de Genética Humana de la Universidad de Oxford tal y como describen en Nature Communications, ha logrado implementar un nuevo programa de ordenador (Mykrobe Predictor) que posibilita el análisis rápido del ADN bacteriano. Esto permite predecir cuáles serían los antibióticos que mejor actuarían sobre dicha infección para poder combatirla y cuáles serían los antibióticos frente a los que esas bacterias han generado resistencias.
¿En qué consiste el proceso?
Siempre hemos escuchado hablar de las infecciones asociadas a las estancias hospitalarias (infecciones nosocomiales) que han adquirido pacientes ingresados en hospitales. Sobre todo, cuando padecen enfermedades que implican estancias largas o cuando se trata de pacientes que se encuentran en la unidad de cuidados intensivos.
Tal es así, que cada año el tratamiento y la alteración de pacientes en todo el mundo se complica a causa de infecciones contraídas durante la asistencia médica. De hecho, algunas personas enferman más gravemente por este tipo de infecciones hospitalarias que por las patologías con las que fueron ingresados. Otras, en cambio, alargan su estancia en el hospital y otras quedan discapacitadas por un largo período de tiempo o incluso mueren.
Estas graves consecuencias podrían minimizarse, según el equipo de investigación de Oxford, mediante el empleo del nuevo software que este grupo ha desarrollado. Este programa diseñado por el Dr. Zamin Iqbal y su equipo consiste en un programa de ordenador fácil de usar que puede ejecutarse en un ordenador portátil estándar o tablet y puede ser utilizado por una amplia variedad de profesionales sin experiencia en bioinformática.
Para determinar qué cepa de bacteria está causando la infección y frente a qué tipo de medicamentos es resistente, se llevan a cabo una serie de pruebas de sensibilidad. Para ello, lo que se hace es cultivar la bacteria que está provocando la infección en placas de cultivo. Sobre ellas se añade una batería de antibióticos. Esto permitirá observar cuáles de ellos han sido efectivos y, por tanto, han logrado eliminar o detener el crecimiento de las bacterias. De este modo queda claro que antibiótico será completamente efectivo.
Esto, como es evidente, supone un grave problema para el control de estas infecciones. Por lo tanto, necesitamos con urgencia nuevas estrategias de diagnóstico que permitan dar un mejor uso a los antibióticos y, con ello, salvaguardar la eficacia tanto de los fármacos ya existentes como de los nuevos que se desarrollen en un futuro.
Un grupo de investigadores pertenecientes al Centro Wellcome Trust de Genética Humana de la Universidad de Oxford tal y como describen en Nature Communications, ha logrado implementar un nuevo programa de ordenador (Mykrobe Predictor) que posibilita el análisis rápido del ADN bacteriano. Esto permite predecir cuáles serían los antibióticos que mejor actuarían sobre dicha infección para poder combatirla y cuáles serían los antibióticos frente a los que esas bacterias han generado resistencias.
¿En qué consiste el proceso?
Siempre hemos escuchado hablar de las infecciones asociadas a las estancias hospitalarias (infecciones nosocomiales) que han adquirido pacientes ingresados en hospitales. Sobre todo, cuando padecen enfermedades que implican estancias largas o cuando se trata de pacientes que se encuentran en la unidad de cuidados intensivos.
Tal es así, que cada año el tratamiento y la alteración de pacientes en todo el mundo se complica a causa de infecciones contraídas durante la asistencia médica. De hecho, algunas personas enferman más gravemente por este tipo de infecciones hospitalarias que por las patologías con las que fueron ingresados. Otras, en cambio, alargan su estancia en el hospital y otras quedan discapacitadas por un largo período de tiempo o incluso mueren.
Estas graves consecuencias podrían minimizarse, según el equipo de investigación de Oxford, mediante el empleo del nuevo software que este grupo ha desarrollado. Este programa diseñado por el Dr. Zamin Iqbal y su equipo consiste en un programa de ordenador fácil de usar que puede ejecutarse en un ordenador portátil estándar o tablet y puede ser utilizado por una amplia variedad de profesionales sin experiencia en bioinformática.
Para determinar qué cepa de bacteria está causando la infección y frente a qué tipo de medicamentos es resistente, se llevan a cabo una serie de pruebas de sensibilidad. Para ello, lo que se hace es cultivar la bacteria que está provocando la infección en placas de cultivo. Sobre ellas se añade una batería de antibióticos. Esto permitirá observar cuáles de ellos han sido efectivos y, por tanto, han logrado eliminar o detener el crecimiento de las bacterias. De este modo queda claro que antibiótico será completamente efectivo.
Rapidez y efectividad en el proceso
El problema de todo el procedimiento descrito es el tiempo. Es un proceso que puede tardar días o incluso meses, en función de la rapidez o lentitud de crecimiento de las bacterias en las placas de cultivo. Además, si la bacteria porta alguna mutación que confiera resistencia, no puede ser detectada mediante esta tecnología.
Por lo que, los científicos consideran que podría obtenerse gran cantidad de información, pero de forma más rápida, centrándose directamente en la secuencia del ADN bacteriano. Ésta es una técnica que tiene el potencial de transformar la forma de diagnosticar y tratar las infecciones bacterianas en los hospitales. Es más concreta y con su aplicación es posible la detección de posibles alteraciones genéticas responsables de las resistencias generadas frente a los antibióticos.
Sin embargo, la interpretación de la información genética obtenida requiere, a menudo, un gran potencial informático, así como, de especialistas con experiencia en bioinformática. Por tanto, el tiempo “perdido” en todo este proceso, puede ser causa de importantes fatalidades.
El software diseñado por este grupo de investigación agiliza todo este proceso mediante la automatización de análisis del genoma. Gestiona los datos obtenidos tras la secuenciación de una forma rápida. Concretamente, en menos de 3 minutos genera un informe médico en el que se muestran los resultados de una forma sencilla de entender y en un ordenador portátil estándar. Esto les permite cotejar el genoma de la bacteria causante de la infección con el de cepas anteriores, iniciándose así la búsqueda de posibles mutaciones causantes de la resistencia.
Ventajas de Mycrobe predictor
Los investigadores realizaron el estudio en más de 4500 muestras de pacientes, en el que comprobaron que el Mykrome predictor detectaba con precisión la resistencia a antibióticos en dos infecciones bacterianas potencialmente mortales, una causada por la bacteria responsable de infecciones nosocomiales (Staphylococcus aureus) y la otra la responsable de la tuberculosis (Mycobacterium tuberculosis).
Una de las principales ventajas del programa es que, incluso, puede identificar infecciones donde el cuerpo de un paciente contiene una mezcla de bacterias formada por bacterias fármaco resistentes y bacterias fármaco sensibles. Esto supone una enorme ventaja sobre las pruebas convencionales, por ejemplo, para la detección de resistencia a fármacos de las bacterias causantes de la tuberculosis, resistente por lo menos a cuatro de los medicamentos básicos.
Todo esto trae consigo una mejora en la toma de decisiones, ya que serán más específicas y adecuadas, lo que, repercute directamente en la salud del paciente. De hecho, el software ya se está probando en tres hospitales del Reino Unido para estudiar si podría ayudar a acelerar el diagnóstico de las infecciones resistentes a los fármacos, lo que orientaría a los médicos a realizar una mejor prescripción de antibióticos.
Ahora, uno de los principales retos es desarrollar herramientas adecuadas para que se pueda desbloquear la información obtenida en la secuenciación del ADN de una forma rápida y asequible. Por lo que el objetivo final de este equipo, es proporcionar información completa sobre un patógeno dentro de las 24 horas de cultivo, vinculando esta información a una base de datos nacional que permita el tratamiento específico y adecuado para la eliminación de la infección de un paciente.
El problema de todo el procedimiento descrito es el tiempo. Es un proceso que puede tardar días o incluso meses, en función de la rapidez o lentitud de crecimiento de las bacterias en las placas de cultivo. Además, si la bacteria porta alguna mutación que confiera resistencia, no puede ser detectada mediante esta tecnología.
Por lo que, los científicos consideran que podría obtenerse gran cantidad de información, pero de forma más rápida, centrándose directamente en la secuencia del ADN bacteriano. Ésta es una técnica que tiene el potencial de transformar la forma de diagnosticar y tratar las infecciones bacterianas en los hospitales. Es más concreta y con su aplicación es posible la detección de posibles alteraciones genéticas responsables de las resistencias generadas frente a los antibióticos.
Sin embargo, la interpretación de la información genética obtenida requiere, a menudo, un gran potencial informático, así como, de especialistas con experiencia en bioinformática. Por tanto, el tiempo “perdido” en todo este proceso, puede ser causa de importantes fatalidades.
El software diseñado por este grupo de investigación agiliza todo este proceso mediante la automatización de análisis del genoma. Gestiona los datos obtenidos tras la secuenciación de una forma rápida. Concretamente, en menos de 3 minutos genera un informe médico en el que se muestran los resultados de una forma sencilla de entender y en un ordenador portátil estándar. Esto les permite cotejar el genoma de la bacteria causante de la infección con el de cepas anteriores, iniciándose así la búsqueda de posibles mutaciones causantes de la resistencia.
Ventajas de Mycrobe predictor
Los investigadores realizaron el estudio en más de 4500 muestras de pacientes, en el que comprobaron que el Mykrome predictor detectaba con precisión la resistencia a antibióticos en dos infecciones bacterianas potencialmente mortales, una causada por la bacteria responsable de infecciones nosocomiales (Staphylococcus aureus) y la otra la responsable de la tuberculosis (Mycobacterium tuberculosis).
Una de las principales ventajas del programa es que, incluso, puede identificar infecciones donde el cuerpo de un paciente contiene una mezcla de bacterias formada por bacterias fármaco resistentes y bacterias fármaco sensibles. Esto supone una enorme ventaja sobre las pruebas convencionales, por ejemplo, para la detección de resistencia a fármacos de las bacterias causantes de la tuberculosis, resistente por lo menos a cuatro de los medicamentos básicos.
Todo esto trae consigo una mejora en la toma de decisiones, ya que serán más específicas y adecuadas, lo que, repercute directamente en la salud del paciente. De hecho, el software ya se está probando en tres hospitales del Reino Unido para estudiar si podría ayudar a acelerar el diagnóstico de las infecciones resistentes a los fármacos, lo que orientaría a los médicos a realizar una mejor prescripción de antibióticos.
Ahora, uno de los principales retos es desarrollar herramientas adecuadas para que se pueda desbloquear la información obtenida en la secuenciación del ADN de una forma rápida y asequible. Por lo que el objetivo final de este equipo, es proporcionar información completa sobre un patógeno dentro de las 24 horas de cultivo, vinculando esta información a una base de datos nacional que permita el tratamiento específico y adecuado para la eliminación de la infección de un paciente.
Referencia bibliográfica:
Bradley P y col. Rapid antibiotic-resistance predictions from genome sequence data for Staphylococcus aureus and Mycobacterium tuberculosis. Nature Communications (2015). DOI: 10.1038/ncomms10063.
Bradley P y col. Rapid antibiotic-resistance predictions from genome sequence data for Staphylococcus aureus and Mycobacterium tuberculosis. Nature Communications (2015). DOI: 10.1038/ncomms10063.

 Tendencias Científicas
Tendencias Científicas

El corazón débil también daña al cerebro
El corazón débil también daña al cerebro CIENCIA ON LINE
CIENCIA ON LINE